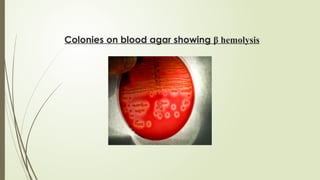
Colonies on blood agar showing β hemolysis
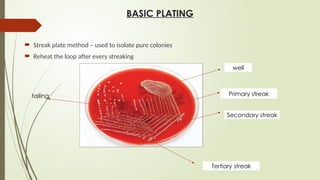
BASIC PLATING
 Streak plate method – used to isolate pure colonies
 Reheat the loop after every streaking
well
Primary streak
Secondary streak
Tertiary streak
tailing

The document outlines microbiology laboratory procedures for specimen collection and processing, including blood, urine, pus, cerebrospinal fluid (CSF), and stool. It details various techniques such as Gram staining, automated blood culture systems (Bactec and Vitek), and molecular methods for diagnosing infectious diseases. Additional information covers culture media used, antibiotic susceptibility testing, and identification of pathogens through biochemical tests.